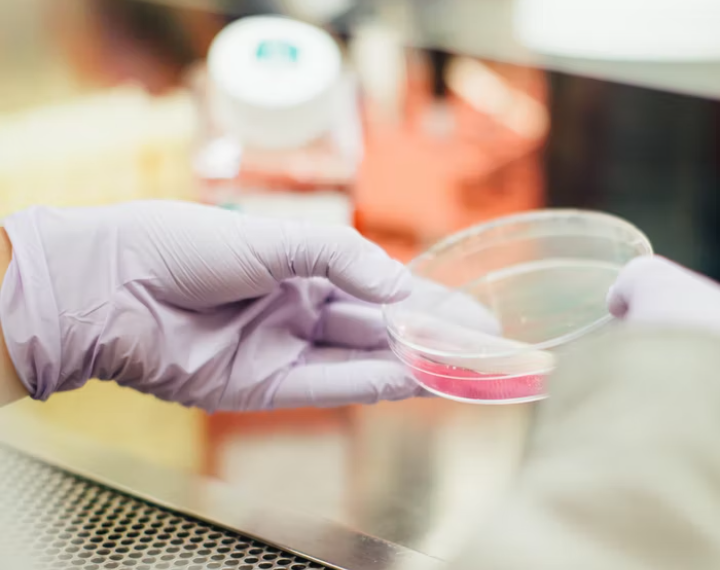
السلطات الصحية في ميشغان تؤكد تسجيل 43 إصابة بالإشريكية القولونية

أكدت السلطات الصحية في ميشغان تسجيل 43 إصابة بالإشريكية القولونية تطابق سلالة الإشريكية القولونية O157.
حيث تم الأبلاغ عن أكثر من %55 من حالات تفشي المرض عن تناول الطعام في مطعم Wendy دون تحديد مصدر طعام معين حتى الآن، لكن المسؤولين يركزون على السندويشات التي تحتوي على الخس الروماني.
في حين لم تصدر حتى الآن أي توصيات بشأن تجنب تناول الطعام في مطعم Wendy و الذي يعمل مع إدارات الصحة العامة المحلية لسحب بعض المنتجات.
هذا و تتراوح تواريخ ظهور المرض من أواخر شهر تموز/يوليو الفائت حتى أوائل آب/أغسطس الحالي.
و قد تم الإبلاغ عن حالات تفشي المرض في المقاطعات التالية : Allegan و Branch و Clinton و Genesee و Gratiot و Jackson و Kent و Macomb و Midland و Monroe و Muskegon و Oakland و Ogemaw و Ottawa و Saginaw و Washtenaw و Wayne و Detroit.
ما يقوله مركز السيطرة على الأمراض
لا ينصح مركز السيطرة على الأمراض CDC الأشخاص بتجنب تناول الطعام في مطاعم Wendy أو أن يتوقف الناس عن تناول الخس.
في حين تتخذ Wendy الإجراء الاحترازي لإزالة الخس الروماني المستخدم في السندويشات من المطاعم في هذه المنطقة.
و حتى الآن لا يوجد دليل يشير إلى أن الخس الروماني الذي يباع في محلات البقالة أو يقدم في مطاعم أخرى أو في منازل الناس مرتبط بهذا التفشي.
و سيقوم CDC بتحديث هذه النصيحة إذا حدد التحقيق الأطعمة التي يجب تجنبها.
ما هي الإشريكية القولونية أو E. coli ؟
الإشريكية القولونية أو E. coli هي بكتيريا توجد في البيئة والأطعمة وأمعاء البشر والحيوانات.
و بحسب CDC فإن معظم السلالات غير ضارة، لكن بعضها يمكن أن يصيب الناس بالمرض.
حيث يمكن أن تسبب بعض السلالات الإسهال و التهابات المسالك البولية و أمراض الجهاز التنفسي و الالتهاب الرئوي من بين أمراض أخرى.
ما هي أعراض الأمراض المرتبطة بالإشريكية القولونية ؟
تختلف الأعراض من شخص لآخر لكنها غالباً ما تشمل تقلصات شديدة في المعدة و إسهال و قيء.
كما يعاني بعض الأشخاص من حمى لا تكون شديدة في العادة.
و يشعر معظم الناس بالتحسن في غضون خمسة إلى سبعة أيام.
و تظهر الأعراض عادة بعد ثلاثة إلى أربعة أيام من التعرض و لكنها قد تظهر في يوم واحد فقط أو حتى 10 أيام، و من الممكن أن يكون الأطفال الصغار و كبار السن أكثر عرضة للإصابة بأمراض خطيرة.
و من الجدير بالذكر أن حوالي %5 إلى %10 من الأشخاص الذين تم تشخيص إصابتهم بالعدوى يصابون بمتلازمة انحلال الدم اليوريمي و التي تظهر بعد 7 أيام من بدء الأعراض.
ما يمكن فعله للوقاية من الإشريكية القولونية ؟
يشمل الأشخاص المعرضون لفرص أعلى للإصابة بالأمراض المنقولة بالغذاء النساء الحوامل و حديثي الولادة و الأطفال و كبار السن و الذين يعانون من ضعف في جهاز المناعة مثل الأشخاص المصابين بالسرطان أو مرض السكري أو فيروس نقص المناعة البشرية / الإيدز.
و وفقاً لمسؤولي الصحة فإنه يمكن منع الإصابة بالأمراض المرتبطة بالإشريكية القولونية باتباع ممارسات نظافة اليدين و تداول الطعام.
حيث يذكر مركز السيطرة على الأمراض الممارسات الوقائية التالية :
اغسل يديك جيداً بعد استخدام الحمام أو تغيير الحفاضات.
اغسل يديك جيداً قبل و بعد تحضير الطعام أو تناوله.
اغسل يديك جيداً بعد ملامسة الحيوانات أو بيئتها ( في المزارع وحدائق الحيوانات الأليفة و حتى الفناء الخلفي الخاص بك ).
اغسل يديك جيداً قبل تحضير الزجاجات أو الأطعمة وإطعامها لرضيع أو طفل صغير قبل لمس فم الرضيع و قبل لمس اللهايات أو الأشياء الأخرى التي تدخل فم الرضيع أو الطفل الصغير.
في حالة عدم توفر الماء و الصابون استخدم معقم يدين يحتوي على كحول بنسبة %60 على الأقل.